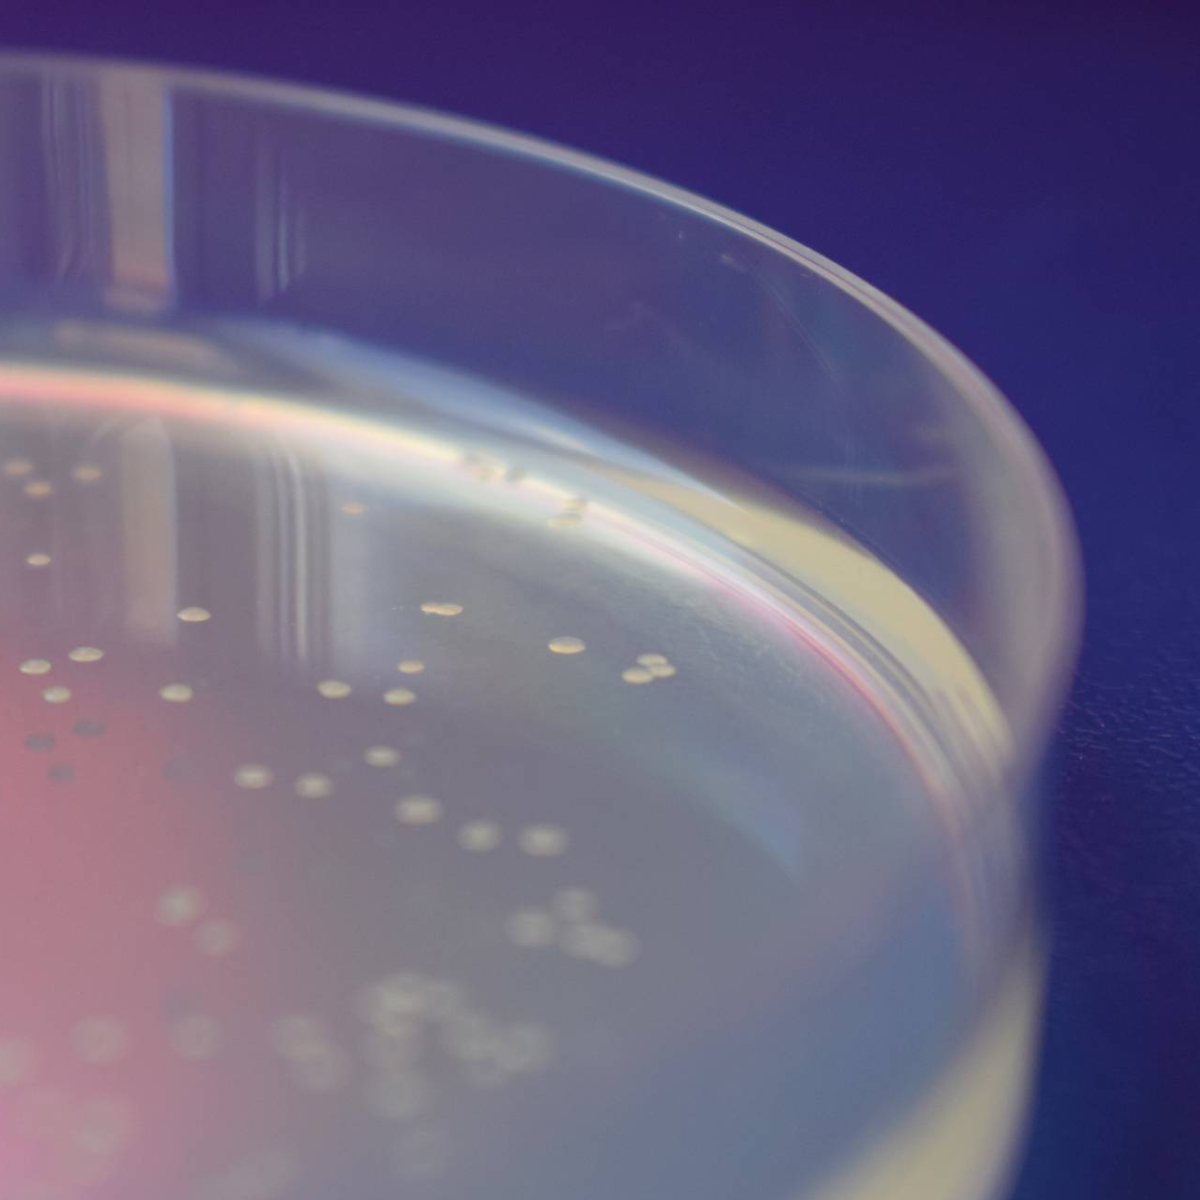
Bacterial Protein Expression

Bacterial Protein Expression
Manufacturing
Information
Choosing bacterial expression systems for the production of recombinant proteins, offers several advantages: A shorter timeline for the entire process from cloning to protein recovery, inexpensive production processes, high protein yields and a high flexibility in scale.
While this expression system is not suitable for every project, smaller peptides and recombinant proteins without posttranslational modifications can easily be expressed in E. coli. InVivo`s protein experts are happy to help you choose the right expression system for your application.
For protein expression in E. coli, we offer a huge selection of different culture vessels (2 L shaker flasks to 50 L bioreactors) to ensure that we can meet all your needs. Furthermore, 10 L bioreactors (OD 30-80) are available for high cell density cultivation.
Our services include:
cDNA synthesis and cloning into protein expression vector (including codon optimization and attachment of tag (e.g. HIS-tag) for subsequent protein purification)
Small scale pilot production to assess the feasibility of expression and purification of your protein of interest (Feasibility Study)
Large scale production after successful test production